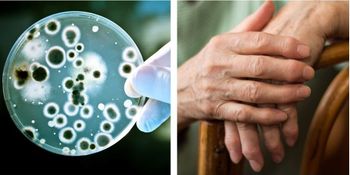
Glucocorticoids and Biologics Share Similar Infection Risk in Rheumatoid Arthritis

This week, Rheumatology Network interviewed Michael C. Schweitz, MD, to discuss the recent press release published by CreakyJoints that announced their partnership with the John Whelton Arthur Virshup CreakyJoints South Florida Arthritis Clinic.


This week, Rheumatology Network interviewed Michael C. Schweitz, MD, to discuss the recent press release published by CreakyJoints that announced their partnership with the John Whelton Arthur Virshup CreakyJoints South Florida Arthritis Clinic.

Most women experience a decrease in the severity of their rheumatoid arthritis (RA) symptoms during pregnancy, but some may need ongoing treatment. Test your knowledge of the treatment of RA during pregnancy.

In this video, Jack March, a physiotherapist specializing in rheumatology, demonstrates exercises for rheumatoid arthritis (RA) relief. He discusses providing exercises for patients, how to prescribe them, reasons to get patients to exercise, and the many benefits that come from engaging in a workout routine.

Although associated with adverse effects, glucocorticoids are effective for managing rheumatoid arthritis (RA) symptoms and are prescribed to most patients. Test your knowledge of the prescription of glucocorticoids in RA with this quiz.

Older adults who self-report rheumatoid arthritis (RA) do not have a Medicare claims history consistent with their diagnosis, according to study.

Research suggests that adults who experienced 2 or more traumatic events during childhood are at a 100% increased risk to develop rheumatic disease.

Patients with rheumatoid arthritis (RA) believe that prednisolone is a necessary medication, yet they are cautious about taking it due to the adverse effects, according to a new study.

Investigators believe inflammation, which is known to begin before rheumatoid arthritis (RA) symptoms appear, may be a main factor in the increased prevalence and incidence in multimorbidity for patients with RA.

Some treatments for rheumatic diseases have shown promise for treating COVID-19, but many should be avoided in patients with confirmed or suspected COVID-19. How much do you know about the use of treatments for rheumatic diseases in patients with COVID-19? Take our quiz to find out.

Rheumatology Network sat down with Liana Fraenkel, MD, MPH, the lead investigator for the study: OPEX: Development of a novel overall patient experience measure to facilitate interpretation of comparison effectiveness studies. In partnership with CreakyJoints, Fraenkel is a rheumatologist at Berkshire Medical Center and Director of Patient Centered Population Health Research.

The American College of Rheumatology (ACR) has recently issued conditional recommendations on the coronavirus disease 2019 (COVID-19) vaccination for rheumatology patients with musculoskeletal, inflammatory, and autoimmune diseases. The recommendations are focused on the 2 mRNA COVID-19 vaccines currently available in the United States and are based on experience using immunomodulatory medications with other vaccines. The recommendations will be reviewed as additional COVID-19 vaccines are approved for use and more information on vaccine response specific to rheumatic disease patients emerges. Test your knowledge of the special considerations recommended for COVID-19 vaccination of patients with rheumatic diseases.

Rheumatology Network interviewed Roy Fleischmann, MD, to discuss his presentations for the Rheumatology Winter Clinical Symposium. He is presenting his findings on Combination Therapy in Rheumatology and Rheumatology 2020: A Year in Review of Novel Therapies.

Patients with rheumatoid arthritis are known to have a greater risk of serious infections related both to the disease itself and its treatment. What can be done to reduce that risk? Test your knowledge with this quiz.

This week's rheumatoid arthritis quiz was developed by Fotios Koumpouras, MD, Director of Education and Training and Director of the Yale Lupus Program at Yale School of Medicine.

In a new study, investigators set out to discover whether the Janus kinase-1 inhibitor filgotinib is efficacious, either in combination with MTX or as monotherapy, in patients with RA who have had limited or no MTX exposure.

A recent study published in The Journal of Rheumatology found no association between hydroxychloroquine therapy and heart failure in patients with rheumatoid arthritis (RA) and other rheumatic diseases, such as systemic lupus erythematous (SLE).

Despite the limitations of the study, non-adherence rates were significantly reduced in patients observed throughout the 3 years, indicating that the methods developed and deployed were successful.

Investigators aimed to improve the quality of care by creating effective management plans using the goals of both the patient and physician. During the course of the Elderly Multimorbidity Clinic (EMC) program, 75% of patients accomplished at least 1 of their goals. Unfortunately, no sustained benefits were observed because of low follow-up.

A range of biologic therapies are available as options for treating patients with rheumatoid arthritis who do not respond to first-line conventional DMARDs, but which to choose and why? Test your knowledge of biologics with this quiz.

“The most important take home message for rheumatologists is that we can predict lack of response to methotrexate by analyzing the fecal microbiome of patients before the initiation of the treatment,” said Jose Scher, MD, rheumatologist from the Department of Medicine, Mount Sinai School of Medicine, New York.

Although the stakes couldn’t be higher and the promotion of healthy behavior is paramount, the emphasis on BMI and weight is likely to yield little benefit. The Association for Size Diversity and Health (ASDAH) developed Health at Every Size (HAES) to take the focus off of weight change and place it more squarely on health, thus supporting people of all sizes to take care of themselves and improve health outcomes.

Previously proven to be an effective and well-tolerated treatment for patients with RA, baricitinib can also help patients reduce joint damage progression and erosion.

Coupled with the fact that there were no new safety concerns identified, these findings further solidify the safety and effectiveness of abatacept for RA patients.

The study is the first randomized trial to examine the comparative benefits and safety of biological drugs with different modes of action versus active conventional treatment.
Continued use of low dose glucocorticoid in patients with rheumatoid arthritis also treated with stable DMARD therapy is associated with a small but significant risk of serious infection, show the results of a study published in Annals of Internal Medicine.